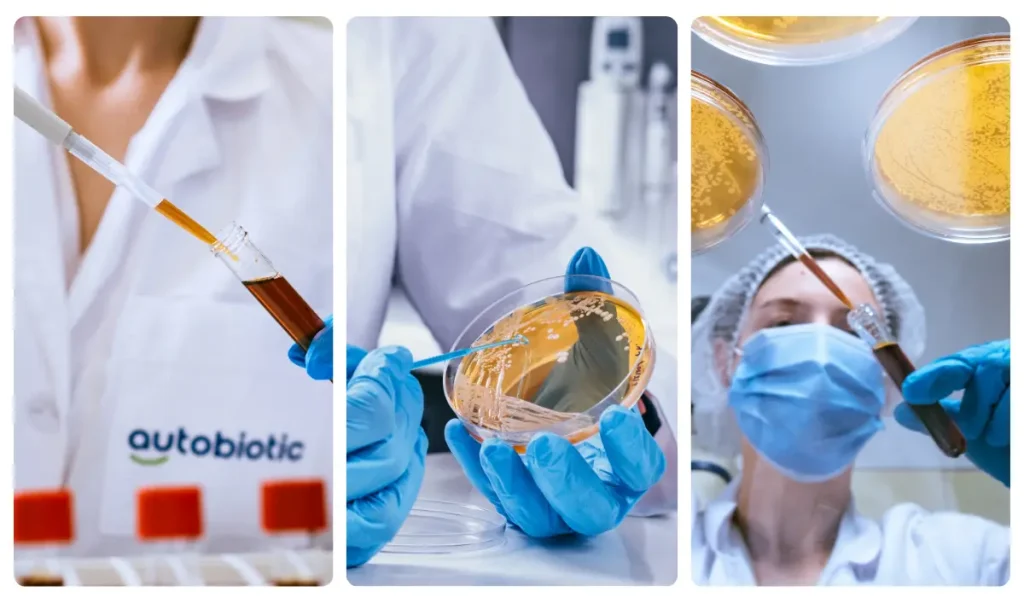

Η ρήση του Ιπποκράτη: «Όλες οι ασθένειες ξεκινούν από το έντερο» – επίκαιρη από τον 5ο αιώνα π.Χ. έως σήμερα, με τη δύναμη του επαναστατικού Μεταβιοτικού Bibiotic.
Αν ο Ιπποκράτης — θεωρούμενος πατέρας της ιατρικής — μπορούσε να ρίξει μια ματιά σε ένα σύγχρονο εργαστήριο, πιθανότατα θα χαμογελούσε με κατανόηση. Γιατί ήδη πριν από περισσότερες από δύο χιλιετίες δήλωνε: «Όλες οι ασθένειες ξεκινούν από το έντερο» — μια ιδέα που σήμερα η επιστήμη επιβεβαιώνει με εντυπωσιακή ακρίβεια.
Παρόλο που ο αρχαίος Έλληνας ιατρός δεν διέθετε τους όρους που χρησιμοποιούμε σήμερα — μικροβίωμα, μεταβολίτης, μεταβιοτικό — η διαίσθησή του κατευθυνόταν ακριβώς σε αυτό που η σύγχρονη ιατρική τοποθετεί στο επίκεντρο: την υγεία του πεπτικού συστήματος ως θεμέλιο της συνολικής σωματικής και ψυχικής ευεξίας.
Προβιοτικό έναντι μεταβιοτικού – τι είναι σημαντικό να γνωρίζουμε;
Έχετε ακούσει για τα προβιοτικά – βακτήρια που υποστηρίζουν την καλή ισορροπία στο έντερο. Έχετε όμως ακούσει για τα μεταβιοτικά; Αποτελούν την επόμενη μεγάλη ανακάλυψη στην επιστήμη της υγείας του εντέρου και του ανοσοποιητικού συστήματος.
Ενώ τα προβιοτικά πρέπει να εγκατασταθούν στο έντερο και να βρουν εκεί κατάλληλες συνθήκες για να αναπτυχθούν, ώστε να παράγουν τους απαραίτητους για τον οργανισμό μεταβολίτες — κάτι που απαιτεί χρόνο και ειδικές προϋποθέσεις που δεν υπάρχουν πάντα — τα μεταβιοτικά παρέχουν όλους αυτούς τους μεταβολίτες άμεσα και έτοιμους.
Από εδώ προκύπτει και η λογική ιδέα – αντί να λαμβάνονται προβιοτικά με την ελπίδα ότι θα προσαρμοστούν και θα αρχίσουν να παράγουν τις απαραίτητες ουσίες, γιατί να μη χορηγούνται απευθείας οι έτοιμοι μεταβολίτες;
Έτσι διαμορφώνεται η έννοια των μεταβιοτικών – μια νέα γενιά προϊόντων που προσφέρουν ήδη παραγόμενες, ενεργές ενώσεις, έτοιμες να χρησιμοποιηθούν από τον οργανισμό, χωρίς ανάγκη αποικισμού, προσαρμογής ή αναμονής. Ενώ τα προβιοτικά εξαρτώνται από πολλούς παράγοντες – περιβάλλον, χρόνο, ανταγωνισμό στο έντερο – τα μεταβιοτικά δρουν εδώ και τώρα, παρέχοντας τα απαραίτητα μόρια άμεσα.
Ποια είναι τα οφέλη των μεταβιοτικών;
Τα μεταβιοτικά υποστηρίζουν ένα υγιές εντερικό περιβάλλον, τρέφουν τα ωφέλιμα βακτήρια και προστατεύουν από την εντερική δυσβίωση – μια κατάσταση κατά την οποία διαταράσσεται η ισορροπία μεταξύ «καλών» και «κακών» βακτηρίων. Βοηθούν σε φούσκωμα, διάρροια, πόνους και σπασμούς, αποκαθιστούν τον εντερικό φραγμό και διατηρούν την οξύτητα, ώστε να μην αναπτύσσονται επιβλαβή μικρόβια.
Ενώσεις όπως το βουτυρικό, το οξικό, το γαλακτικό και το κινολινικό οξύ όχι μόνο βελτιώνουν την κατάσταση των εντερικών κυττάρων, αλλά έχουν και αντιφλεγμονώδη δράση. Αυτό τα καθιστά ιδιαίτερα χρήσιμα σε χρόνιες εντερικές παθήσεις όπως το σύνδρομο ευερέθιστου εντέρου, η ελκώδης κολίτιδα κ.ά.
Μεταβιοτικά κατά τη λήψη αντιβιοτικών
Πολλοί άνθρωποι λαμβάνουν προβιοτικά κατά τη διάρκεια αντιβιοτικής θεραπείας, αλλά συχνά δεν γνωρίζουν ότι τα αντιβιοτικά καταστρέφουν και τα ωφέλιμα βακτήρια – συμπεριλαμβανομένων αυτών των προβιοτικών. Τα μεταβιοτικά δεν περιέχουν ζωντανά βακτήρια, γεγονός που τα καθιστά πολύ πιο αποτελεσματικά σε αυτή την περίπτωση. Αντισταθμίζουν την έλλειψη μεταβολιτών και προστατεύουν από ανεπιθύμητες ενέργειες όπως διάρροια, ναυτία και φούσκωμα.
Ανοσία και μεταβιοτικά
Τα μεταβιοτικά υποστηρίζουν το ανοσοποιητικό σύστημα, διεγείροντας τη δραστηριότητα βασικών ανοσοκυττάρων και ρυθμίζοντας τις φλεγμονές. Για παράδειγμα, το οξικό και το γαλακτικό ενεργοποιούν τα Τ-κύτταρα, τα οποία προστατεύουν από αυτοάνοσες αντιδράσεις. Άλλες ενώσεις καταστέλλουν τις υπερβολικές φλεγμονώδεις αποκρίσεις και συμβάλλουν έτσι στη δημιουργία ισορροπίας. Αυτό οδηγεί σε καλύτερη προστασία από ιούς, βακτήρια και αλλεργίες.
Ποια είναι η θέση των μεταβιοτικών στη σύγχρονη διατροφή;
Σήμερα τα μεταβιοτικά βρίσκουν ολοένα και ευρύτερη εφαρμογή σε συμπληρώματα διατροφής και λειτουργικά τρόφιμα. Χρησιμοποιούνται για την ενίσχυση του εντερικού φραγμού, τη βελτίωση της ανοσίας και τη μείωση των φλεγμονών. Και παρόλο που η επιστήμη δεν έχει ακόμη αποκαλύψει πλήρως όλους τους μηχανισμούς, ένα είναι βέβαιο – η υγεία μας συνδέεται στενά με το μικροβίωμα, τη μικροβιακή χλωρίδα και το μεταβόλωμα.
Συμπερασματικά…
Τα μεταβιοτικά αποτελούν το επόμενο βήμα στη φροντίδα της υγείας του εντέρου και του ανοσοποιητικού συστήματος…
Στρατηγικός μετασχηματισμός – από τα προβιοτικά στα μεταβιοτικά – η ιστορία πίσω από το Bibiotic®
Το 2012, η ΕΚΟΚΟΜ Group προχώρησε σε στρατηγικό μετασχηματισμό με τη δημιουργία δικής της βιοτεχνολογικής επιχείρησης – AUTOBIOTIC. Στο πλαίσιο αυτής της κατεύθυνσης ξεκίνησαν εκτεταμένες έρευνες και δοκιμές προβιοτικών προϊόντων για ανθρώπους και ζώα.
Η ανάλυση των συσσωρευμένων δεδομένων οδήγησε σε σαφή συνειδητοποίηση των περιορισμών του κλασικού προβιοτικού μοντέλου – της εξάρτησής του από τις συνθήκες του οργανισμού, της απρόβλεπτης αποίκισης και της μεταβλητότητας του αποτελέσματος. Αυτό κατεύθυνε την εταιρεία προς μια πιο καινοτόμο και επιστημονικά τεκμηριωμένη προσέγγιση: την ανάπτυξη προϊόντων βασισμένων όχι σε ζωντανά βακτήρια, αλλά στους βιολογικά ενεργούς μεταβολίτες τους.
Έτσι γεννήθηκε η έννοια των μεταβιοτικών λύσεων της ΕΚΟΚΟΜ – προϊόντα που περιέχουν έτοιμες βιοενεργές ενώσεις και αδρανοποιημένα βακτηριακά συστατικά, χωρίς παρουσία ζωντανών μικροοργανισμών.
Bibiotic® – η πρακτική εφαρμογή της επιστημονικής προσέγγισης
Το αποτέλεσμα αυτού του μετασχηματισμού είναι η σειρά προϊόντων Bibiotic® – το πρώτο μεταβιοτικό με βιομηχανική παραγωγή στην Ευρώπη, αναπτυγμένο σύμφωνα με τον ορισμό συναίνεσης της ISAPP (2021).
Η παραγωγή πραγματοποιείται στη βιοεπιχείρηση AUTOBIOTIC μέσω ιδιόκτητης πολυσταδιακής διαδικασίας ζύμωσης, υλοποιημένης σε ειδικά σχεδιασμένα συστήματα βιοαντιδραστήρων. Σε αντίθεση με τις τυπικές βιομηχανικές λύσεις που χρησιμοποιούνται στη βιοτεχνολογία, ο εξοπλισμός και οι τεχνολογικές γραμμές έχουν δημιουργηθεί βάσει εξατομικευμένου σχεδίου, αναπτυγμένου από ίδια ομάδα επαγγελματιών με πολυετή πρακτική εμπειρία.
Ο συνδυασμός ιδιοσχεδιασμένου εξοπλισμού, συγκεκριμένων παραμέτρων ζύμωσης και εσωτερικά ανεπτυγμένων τεχνολογικών πρωτοκόλλων εγγυάται σταθερότητα, αναπαραγωγιμότητα και υψηλή ποιότητα του τελικού προϊόντος.
Αλλά το σημαντικότερο είναι ότι αυτή η επιστημονική πλατφόρμα βρίσκει πραγματική εφαρμογή σε λύσεις που απευθύνονται σε συγκεκριμένες ανάγκες του σύγχρονου ανθρώπου.
Η σειρά προϊόντων Bibiotic®
Bibiotic Gastro
Υποστήριξη της εντερικής ισορροπίας
Φόρμουλα που στοχεύει στην αποκατάσταση και διατήρηση του εντερικού φραγμού και της μικροβιακής ισορροπίας.
Υποστηρίζει:
- την εξισορρόπηση της εντερικής μικροχλωρίδας
- τη μείωση των φλεγμονωδών διεργασιών
- την αποκατάσταση του εντερικού φραγμού
Κατάλληλο σε περιπτώσεις δυσβίωσης, συνδρόμου ευερέθιστου εντέρου, εκκολπωματίτιδας, ελκώδους κολίτιδας, λειτουργικών ενοχλήσεων όπως φούσκωμα, αέρια, κοιλιακή δυσφορία, καθώς και πολλών άλλων γαστρεντερολογικών προβλημάτων. Ιδιαίτερα κατάλληλο κατά τη διάρκεια και μετά από αντιβιοτική θεραπεία.
Bibiotic Immuno
Για ισχυρό και ισορροπημένο ανοσοποιητικό σύστημα
Ρυθμίζει την ανοσολογική απόκριση μέσω εξισορρόπησης προφλεγμονωδών και αντιφλεγμονωδών μηχανισμών.
Κατάλληλο σε περιπτώσεις:
- εξασθενημένης ανοσίας
- εποχικών ιώσεων
- αυτοάνοσων καταστάσεων
Bibiotic Derma
Υγιές δέρμα από μέσα προς τα έξω
Υποστηρίζει την κατάσταση του δέρματος μέσω ρύθμισης των φλεγμονωδών διεργασιών στον οργανισμό και εξισορρόπησης του εντερικού περιβάλλοντος.
Συμβάλλει σε:
- ρύθμιση φλεγμονωδών διεργασιών
- εξισορρόπηση της εντερικής μικροχλωρίδας
- βελτίωση της εντερικής φραγμικής λειτουργίας
Bibiotic για παιδιά και ενήλικες
Προσαρμογή σε αλλαγή περιβάλλοντος
Η επιστήμη πίσω από το ήρεμο στομάχι κατά τη διάρκεια ταξιδιού. Το Bibiotic για παιδιά και ενήλικες παρέχει έτοιμους μεταβιοτικούς μεταβολίτες που προετοιμάζουν και προστατεύουν το πεπτικό σύστημα μικρών και μεγάλων ταξιδιωτών.
Εφαρμογή:
- Κατά την αλλαγή διατροφής, καθημερινού ρυθμού και κλίματος σε ταξίδι
- Σε γαστρεντερικές διαταραχές
- Σε γρίπη και άλλες ιογενείς λοιμώξεις
Bibiotic Baby
Υποστήριξη στη βρεφική ηλικία
Αναπτυγμένο για την υποστήριξη της ανάπτυξης της εντερικής μικροβιακής χλωρίδας και του ανοσοποιητικού συστήματος σε βρέφη και μικρά παιδιά.
Εφαρμογή:
- Σε τεχνητή διατροφή
- Σε διατροφικές δυσανεξίες
- Σε κολικούς, δυσκοιλιότητα και διάρροια
- Σε ιογενείς λοιμώξεις
- Κατά τη λήψη αντιβιοτικών
Bibiotic Sensitive
Για ευαίσθητο οργανισμό
Ρυθμίζει με ήπιο τρόπο την ανοσολογική απόκριση, υποστηρίζοντας την ανάπτυξη ανοσολογικής ανοχής.
Κατάλληλο για:
- Ευαίσθητο εντερικό σύστημα
- Ανοσοκατασταλτικές καταστάσεις
- Αλλεργικές εκδηλώσεις
Bibiotic Sport
Ενέργεια, αντοχή και αποκατάσταση
Υποστηρίζει τη μεταβολική αποτελεσματικότητα, μειώνει τις φλεγμονώδεις διεργασίες μετά από καταπόνηση και επιταχύνει την αποκατάσταση.
Συμβάλλει σε:
- Πιο αποτελεσματική πέψη
- Πλήρη απορρόφηση θρεπτικών συστατικών
- Πιο ολοκληρωμένη αποκατάσταση του οργανισμού
- Ενίσχυση των οστών
Η φιλοσοφία πίσω από την καινοτομία
Η φιλοσοφία της ΕΚΟΚΟΜ βασίζεται στην πεποίθηση ότι η πραγματική καινοτομία προκύπτει από την κριτική σκέψη, τη βαθιά κατανόηση των βιολογικών συστημάτων και τη μακροπρόθεσμη δέσμευση στην ποιότητα. Η εταιρεία δεν ακολουθεί τις τάσεις – τις δημιουργεί.
Bibiotic – γιατί η υγεία ξεκινά από μέσα
Σε έναν κόσμο όπου η επιστήμη επιβεβαιώνει ολοένα και πιο ξεκάθαρα τη σύνδεση μεταξύ μικροβιώματος, ανοσίας και συνολικής ευεξίας, τα μεταβιοτικά αποτελούν ένα λογικό και βιώσιμο βήμα προς τα εμπρός.
Το Bibiotic είναι αποτέλεσμα επιστήμης, πολυετούς βιομηχανικής εμπειρίας και οράματος για το μέλλον της μικροβιακής υποστήριξης.
Γιατί ανάμεσα στη βαθιά τεχνολογική γνώση και την καθημερινή φροντίδα της υγείας υπάρχει άμεση σύνδεση – και αυτή ξεκινά από μέσα.

Αν ο Ιπποκράτης ήταν ανάμεσά μας σήμερα, πιθανότατα δεν θα μιλούσε για «ασθένειες που ξεκινούν από το έντερο», αλλά για μικροβίωμα, μεταβολίτες και μεταβιοτικά. Όμως το μήνυμά του θα παρέμενε το ίδιο: η φροντίδα του εντέρου είναι φροντίδα ολόκληρου του οργανισμού.
Γιατί ανάμεσα στην αρχαία σοφία και τη σύγχρονη επιστήμη υπάρχει ένας αδιάρρηκτος δεσμός – η ευημερία σας.









